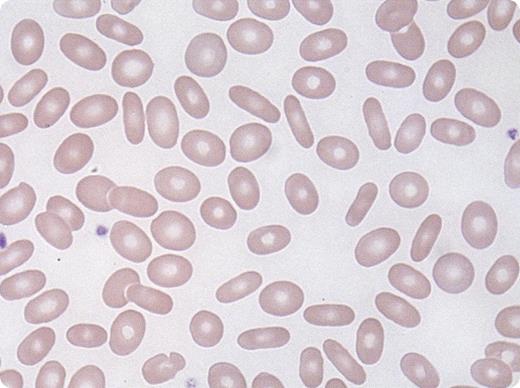
A 21-year-old African-American woman presented for routine prenatal care for her second pregnancy. Her past medical history included normocytic anemia of uncertain etiology, which was treated with iron, during her first pregnancy. At presentation, her physical examination was normal. She had a normocytic anemia (hemoglobin, 9.4 g/dL; mean corpuscular volume, 81 fL; red cell distribution width, 15.3%) with normal leukocyte and platelet counts. Routine high-performance liquid chromatography for a hemoglobinopathy was normal. A peripheral blood smear, which is routinely reviewed in all cases submitted for hemoglobinopathy testing, showed abundant elliptocytes (see figure), essentially diagnostic of hereditary elliptocytosis (HE). It appeared that a peripheral blood smear had not previously been reviewed in this patient. / HE is a heterogeneous group of disorders caused by various mutations in a number of different genes ultimately affecting red cell cytoskeleton and membrane protein integrity. Most cases of HE are due to mutations in the α-spectrin, β-spectrin, or protein 4.1 genes. Single nucleotide substitutions, insertions, deletions, and defective RNA processing have all been identified. HE is seen in numerous ethnic groups; the incidence is highest in west and central Africans. Most patients with heterozygous HE are asymptomatic, although some may demonstrate hemolytic anemia and splenomegaly. This report demonstrates the need for review of the smear in any case of anemia diagnosis. This is especially important at the time of pregnancy, as infants born to a mother with HE may develop significant neonatal hemolytic anemia and hyperbilirubinemia, occasionally with a clinical phenotype indistinguishable from hereditary pyropoikilocytosis.

A 21-year-old African-American woman presented for routine prenatal care for her second pregnancy. Her past medical history included normocytic anemia of uncertain etiology, which was treated with iron, during her first pregnancy. At presentation, her physical examination was normal. She had a normocytic anemia (hemoglobin, 9.4 g/dL; mean corpuscular volume, 81 fL; red cell distribution width, 15.3%) with normal leukocyte and platelet counts. Routine high-performance liquid chromatography for a hemoglobinopathy was normal. A peripheral blood smear, which is routinely reviewed in all cases submitted for hemoglobinopathy testing, showed abundant elliptocytes (see figure), essentially diagnostic of hereditary elliptocytosis (HE). It appeared that a peripheral blood smear had not previously been reviewed in this patient.
HE is a heterogeneous group of disorders caused by various mutations in a number of different genes ultimately affecting red cell cytoskeleton and membrane protein integrity. Most cases of HE are due to mutations in the α-spectrin, β-spectrin, or protein 4.1 genes. Single nucleotide substitutions, insertions, deletions, and defective RNA processing have all been identified. HE is seen in numerous ethnic groups; the incidence is highest in west and central Africans. Most patients with heterozygous HE are asymptomatic, although some may demonstrate hemolytic anemia and splenomegaly. This report demonstrates the need for review of the smear in any case of anemia diagnosis. This is especially important at the time of pregnancy, as infants born to a mother with HE may develop significant neonatal hemolytic anemia and hyperbilirubinemia, occasionally with a clinical phenotype indistinguishable from hereditary pyropoikilocytosis.
A 21-year-old African-American woman presented for routine prenatal care for her second pregnancy. Her past medical history included normocytic anemia of uncertain etiology, which was treated with iron, during her first pregnancy. At presentation, her physical examination was normal. She had a normocytic anemia (hemoglobin, 9.4 g/dL; mean corpuscular volume, 81 fL; red cell distribution width, 15.3%) with normal leukocyte and platelet counts. Routine high-performance liquid chromatography for a hemoglobinopathy was normal. A peripheral blood smear, which is routinely reviewed in all cases submitted for hemoglobinopathy testing, showed abundant elliptocytes (see figure), essentially diagnostic of hereditary elliptocytosis (HE). It appeared that a peripheral blood smear had not previously been reviewed in this patient.
HE is a heterogeneous group of disorders caused by various mutations in a number of different genes ultimately affecting red cell cytoskeleton and membrane protein integrity. Most cases of HE are due to mutations in the α-spectrin, β-spectrin, or protein 4.1 genes. Single nucleotide substitutions, insertions, deletions, and defective RNA processing have all been identified. HE is seen in numerous ethnic groups; the incidence is highest in west and central Africans. Most patients with heterozygous HE are asymptomatic, although some may demonstrate hemolytic anemia and splenomegaly. This report demonstrates the need for review of the smear in any case of anemia diagnosis. This is especially important at the time of pregnancy, as infants born to a mother with HE may develop significant neonatal hemolytic anemia and hyperbilirubinemia, occasionally with a clinical phenotype indistinguishable from hereditary pyropoikilocytosis.
For additional images, visit the ASH IMAGE BANK, a reference and teaching tool that is continually updated with new atlas and case study images. For more information visit http://imagebank.hematology.org.